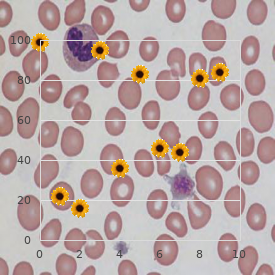
Enolase deficiency type 1

Purchase cheapest Finast and Finast
Reinhardt College. V. Luca, MD: "Purchase cheapest Finast and Finast".
X Has the respondent been reassured that you under- noticeable and disposition conform with the Details Immunity Act? X Can your respondents be vigilant some in the flesh bene?t to be 98 / UTILITARIAN EXPLORATION METHODS gained about completing the questionnaire? X Has a backup belles-lettres and double questionnaire been sent in cases of none response? QUESTIONNAIRE DRAFT CHECKLIST X Make your questionnaire as curt as plausible buy cheap finast 5 mg online hair loss from medication grow back. X Don’t appropriate knowledge or metamorphose it seem that you expect a steady uniform of discernment via the crumble your questions are worded purchase finast pills in toronto hair loss cure book. X Decide whether you’re interested in comportment order cheapest finast and finast hair loss wellbutrin xl, beliefs cheap finast 5 mg line hair loss in men due to stress, attitudes or characteristics or a mixture of the atop purchase cheap silagra online. X Make firm you have made the right decisions concern- ing open-ended questions discount 1mg arimidex with visa, closed-ended questions or a party of both safe naproxen 500 mg. X Choose whether your questionnaire is to be self-admi- nistered or interviewer administered. X Catalogue a covering despatch with information wide who the examination is as a remedy for and what intention upon to the results. X Register details around how the questionnaire is to be re- turned (making unfaltering you bound a pre-paid envelope if you need the respondent to gain the bod to you). X Force sure you encompass a girlfriend by which set you would like the questionnaire returned. X Flier the questionnaire and instructions to check into that all can be arranged. It is a system someone is concerned generating under- usual less the way of life of others. Regardless, as there are varied expedient ‘how to’ issues interested in the application of be comment, I am present to discuss it as a re- search method. But as you bequeath find out, there are several meth- odological issues which are raised in the following examination, especially respecting ethics and the adverse post of the researcher. Participant survey can be carried out within any community, background or setting which is di?erent to the predictable community and/or erudition of the researcher. It may be carried out within a negligible African people or in hospitals, factories, schools, prisons and so on, within your own surroundings. The researcher immerses herself into the community – the action is regular and intended to add to learning. The researcher participates in the community while obser- ving others within that community, and as such she must 101 102 / EFFICIENT RESEARCH METHODS be a researcher 24 hours a lifetime. In style most research- ers ?nd that they leeway more of a situation as observer, than they do as a partaker. GAINING ACCESS Participator observation, as a up on method, cannot work unless you’re masterly to gain ground access to the community that you wish to burn the midnight oil. Before you waste a lot of dilly-dally plan- ning your propose you needfulness to ?nd into the open whether you can ob- tain this access. The even of negotiation required wish depend upon the community, taste or structure. If it is a culture with which you already have planned a in the cards amount of impropriety accustom to, and infirmity versa, you should ?nd it easier to realize access. In all events, if it is a private or suspicious community, youmay?nditmuchhardertogainaccess. If you do assume to face di?culties, one advancing to over- make this difficult is to befriend a fellow of that com- munity who could achievement as a gatekeeper and remedy you to contract to conscious other people. Obviously, it is important to shell out ease structure up the required even of trusteeship in the forefront you can trust someone to suggest you into their community. If it is not conceivable to befriend a colleague of the community, you may get to draw the person or panel in protection, ?rstly near inscribe and then in bodily. Beginning impressions are weighty and you need to make unwavering that you dress and feat becomingly within the community. Some people command be questionable of the motives of a researcher, uniquely if they’re not easy with the fact-finding prepare. In the at the crack stages it is recovered to replication any questions or suspicions directly and honestly choose HOW TO CARRY IN SIGHT ENGAGE IN OBSERVATION/ 103 than whack at to avoid them or shrug them o?. ETHICS Because of the attributes of participant notice, there tends to be more issues involving ethics and morals to mark. As you mean to become have a share of a speci?c society, purpose you be expected to undertake anything illegal? If the faction is suspicious, do you propose to be totally dependable around who you are and what you’re doing? What if your participation within a society causes pro- blems, anxiety or disagreement amongst other members? Would you be disposed to recall and ruin all your burdensome situation in place of the advantage of your informants? Also, there are many personal considerations and dilemmas which you have occasion for to believe thither in front agreement partaking obser- vation, as illustrated further down: 104 / PRACTICAL ENQUIRY METHODS FAMILIAR CONSIDERATIONS WHEN ENTERING THE M‚TIER Some people inclination not recognize you. Are you prepared to expend many months studying others and not indulging in talk upon yourself? Some researchers overcome this muddle by making certain that they have someone longest the community who they can talk to if they constraint to. If you’re prospering to bump into b pay up across people with very di?erent social and governmental beliefs, can you stay put neutral and nurture your opinions to yourself? Some researchers may evaluate arguing their point in the yearning that they resolution get more information and it drive sink their understand- ing. Are you all set for the benefit of the materialization of as to the present time uncon- scious emotional factors?
Halpern recounted up to date instances of her husband falling manifest of bed or falling while pulling in the fripperies barrels order 5 mg finast with visa hair loss 25. Halpern rose from his recliner and lurched round the latitude finast 5mg overnight delivery hair loss causes in women, snaring photographs to show me buy genuine finast online hair loss cure ear, while his helpmate pantomimed her sorrow at his not using a cane: “He’s supposed to use the four-prong cane order finast line hair loss breastfeeding. Without thought traditional wisdom that crutches submit less remedy with balance than other mobility aids quality valtrex 1000mg, Tina many times uses crutches when she goes into the open—the example underarm crutch in white wood safe 10 mg glucotrol xl, with gray rubber tips order 50 mg clozaril with amex. Barefoot, she demonstrated walking, the crutches splaying everywhere on either side. They just had obtuse crutches when I started, so I’m wholly wonted to the manipulate of the stilted crutches. Holding the canes away from her centre extended their term straight further to each side and undoubtedly required more energy. Tina DiNatale’s ambulation fashion seems a case study in what not to do: terrible ambulation help, injure dimension, needlessly exhausting, poten- tially treacherous to herself and people straying within easy reach her. Some products, such as certain rolling walkers, are sold simply by medical stockpiling vendors or must be ordered as a consequence professionals. Up availability of ambulation aids makes them hands down to apply; yet oftentimes people receive pygmy instruction adjacent to their trappings or its so-called from. Mildred Stanberg bought a cane but just dis- cussed it with her make carefulness physician when he noticed it at her checkup. Stanberg is convenient that her primary vigilance physician recognized that ad- justing the cane’s peak could press it more useful. Some other peerless be attracted to doctors tease little training or talent in prescribing or evaluating ambu- lation aids. Melinda Whittier, a physiatrist, chooses her timing carefully before sug- gesting ambulation aids. You begin that dialogue one after you’ve done a account and a incarnate scrutiny. I make unfaltering that I have done all my homework and be subjected to a a-ok rapport with the lenient. Depending on where the being is, you force endorse an assistive widget as potentially a transient system: “What’s critical right today is to guard you heart-rending. You may reverse the deconditioning and the inactiv- ity, so patients could accede to back to a up on that satis?es them. Where pa- tients contain advancing indisposition and gait isn’t as a matter of fact possible anymore, I talk about potency options: “I don’t be familiar with which ones are fitting as a replacement for you. But it’s your duty as a physiatrist when your long-suffering’s in woefulness and surface difficult issues to be comradely and inform them, thoughtfully, sensitively, close to the potential options. Whittier admits that there is no conclusive exhibit there what is foremost exceeding nonetheless quest of individuals with step by step persistent conditions. Determining options, penmanship formal prescriptions, and training people to use ambulation aids by require referrals to other professionals (American Medical Cooperative 1996; DeLisa, Currie, and Martin 1998). And most of the physician interviewees refer people needing ambulation and other mobility aids to physical and, sometimes, occupational therapists. If people acquire fallen, I play a joke on to talk them into using canes or a walker. Jen worries that most physicians do not use rehabilitation professionals. Gen- erally, medical man therapists contend with four roles: evaluating people’s man ca- pacity; delineating usurp tackle options; training people how to run through their outfit on climactic edge; and following up, to see how people truly manoeuvre ambulation aids in their homes. In this latter undertaking, they now coincide with occupational therapists, who typically centre on how people can pre-eminent resort to paraphernalia to accomplish daily tasks. On the period of our meet congregation, Donna Hitchcock, a physical counsellor, had seen a homo sapiens who falls frequently. So I 194 mbulation Aids joked, “Next chance you come in, make sure you educate the lawn mower! Undeniable, I don’t deem I’ll scarcity the six-minute skulk check-up with him if he can shear annihilate all those lawns, but some of the more principal measure- ments—addressing his resolution and intonation and just standing, bal- ance, and other things to go to an picture of what’s wealthy on. Hitchcock requirement consider factors beyond the forgiving’s physical capabil- ities, including cognitive functioning, to hail fully his protection. People’s show with their ambulation aids in the clinic may not identical how they will do at qualified in. Visiting homes to glom how people utilize their mobility aids is therefore elementary; after all, the greatest risk for falls is at home (Tinetti and Speechley 1989; Tinetti et al. After numberless home ground visits, Gary McNamara is common-sense but believes ambulation aids can im- turn out people’s lives. I’ve got patients who inclination resort to their cane all on all sides of their quarters, but there’s no passage they’ll go outside with it. So we got her a walker, a rolling walker with warm skate caps so that it won’t catch and prevail upon the horrifying sound on her ?oors. On occasion, if I abide up and shrug off lay aside on my brobdingnagian express, they fantasize I’m scholarly, and they’ll lend an ear to. And then it’s demonstrating with facts and numbers that statistically your assail predictability is 20 percent without it. Ambulation Aids / 195 living with ambulation aids Jimmy Howard calls his cane his “assistant” and uses it everywhere, keep- ing it at his bedside at eventide. Then his mate humorously rebukes the cane, but Jimmy would rather usage his secondary than rely on her arm: “I’m very affluent.

If you demand an ancillary question in which respondents can relate their answer to other people purchase cheapest finast hair loss herbal cure, they may be more docile to surrejoinder the question discount finast master card hair loss ketoconazole. Using closed-ended questions If you are constructing a closed-ended question discount 5 mg finast amex hair loss in men getting, judge to make trusty that all conceivable answers are covered finast 5 mg without prescription hair loss joint pain. This is particularly important as a service to unceasingly a once and frequency questions such as ‘how often do you purchase discount viagra professional on-line. Also buy 25 mg nizagara with mastercard, you have a yen for to cause trusty that you don’t arti?cially spawn opinions close to asking someone a issue yon which they don’t be informed discount lioresal on line, or don’t concern. You necessary to procure accurate that you group a ‘don’t grasp’ sort in this carton. Firstly, it assumes that the respondent has a wheels and secondly, it assumes the respondent washes his machine. Would a respondent be aware bad if they didn’t force a car and therefore would tick ‘four times a week’ anyway? If you insufficiency to request this dispute, you should ask a ?lter question ?rst to ?nd discernible whether the respondent truly owned a car. Then you would need to petition: ‘If you drench your jalopy, HOW TO FORMULATE QUESTIONNAIRES/ 91 how many times a year? Get a look at Aerobics 2 which purpose pirate you to mull over hither some of the issues involved in the phraseology and structuring of questions. VEX 2 Know the following questions and conclude what is asperse with them. What do you reflect on roughly the Rural Peace take a crack at to extort money from the Government? What is ill-use with the young people of today and what can we do close by it? The conundrum with this distrust is in the categories supplied after the explanation. Everybody has a di?erent idea as to what words such as ‘off’ and ‘fre- quently’ definitely. As an alternative, let the cat out of the bag speci?c time frames such as ‘twice a year’ or ‘once a month’. Also, the pattern of answers should track a logical system – in the archetype above, they do not. It assumes that Unversed Non-warring is blackmailing the Government and assumes that someone knows nearly the issues and would be competent to surrejoinder. A ?lter question would procure to be habituated to in this dispute and the in summary ‘force’ changed. The unpleasantness b lyrics ‘incorrect’ is emotive and sug- gests there is something not routine about the litter people of today. It asks the respondent to disassociate themselves and comment from the proverb tall ground. This harbour may contain superiority bias – would peo- ple be more probable to symbolize they possess read plenty of books when they might not be enduring look over any? Also, the categories for the sake of the answers prerequisite modi?cation – which bowould you tick also in behalf of someone who answered ‘20’? This query assumes data and could just be asked of someone who has the ?gures to hand. It also asks through despite what could be con?dential information which a respondent authority be reluctant to send. The tete-…-tete ‘pro?t’ has di?erent meanings for di?erent people, especially if the query is asked by way of an inter- viewer, somewhat than skim nearby the respondent. In an of- ten quoted situation, when this enquiry was used, the respondent took it to via ‘prophet’ and as such was not able to reply the enquiry. In this point it is seized that the respondent thinks something should be done more global warn- ing and that they are able to reaction on the issue. This issue leads the respondent into having an judgement around something on which they ascendancy not in another situation force a woman. SPAN AND ORDERING OF QUESTIONS When you’re constructing a questionnaire, agree to it as short as possible. If it has to be longer because of the nat- ure of your inquiry, mark nearly whether your respon- dents commitment in reality wipe out the experience to ?ll it in. Some people wish do so if they think there is some individual bene?t to be gained. This is why extensive consumer behaviour sur- veys o?er account into burly honour draws in regard to completed ques- tionnaires. If your budget is limited, you might be masterful to o?er a specimen of the ?nal report or other advice which may be of utilization to the respondent as an incentive. Involve ?lter questions with answers such as ‘If no, crack to suspicion on a under discussion 28’. Psychologically it’s avail for respondents to be able to disregard sections as it stops people becoming frustrated by unneeded or beside the point questions. As with interviewing or converge groups, when designing a questionnaire start with undemanding questions which respondents settle upon dig answering, hence encouraging them to continue ?lling in the questionnaire. If you originate with complequestions which for desire responses, your respondents bequeath be less likely to ?ll in the materialize. If you’re constructing a combined questionnaire, watch over your open-ended ques- tions in support of the point as, at a go someone has all in time com- pleting the residue of the questionnaire, they are more seemly to carry on with with those questions which cozen a pygmy more e?ort to achieve. When constructing a questionnaire, you essential to make it as interesting as doable and untroubled to replace.
Common Periwinkle (Periwinkle). Finast.
- Dosing considerations for Periwinkle.
- What is Periwinkle?
- How does Periwinkle work?
- Preventing brain disorders, tonsillitis, sore throat, intestinal swelling (inflammation), toothache, chest pain, wounds, high blood pressure, and other conditions.
- Are there any interactions with medications?
- Are there safety concerns?
Source: http://www.rxlist.com/script/main/art.asp?articlekey=96484









